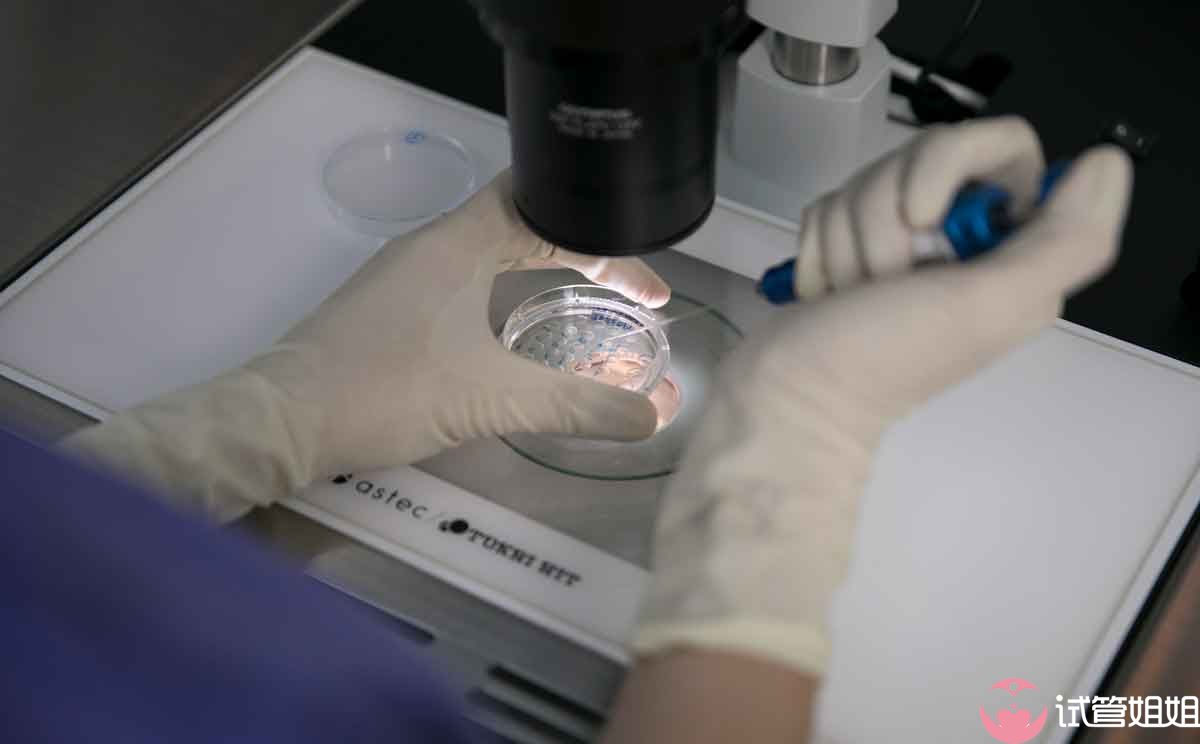

赶紧来测试一下吧!
准妈妈年龄(岁)
备孕难题
试管次数
男方情况
子宫情况
准妈妈AMH(ng/ml)
准妈妈卵泡个数
准妈妈FSH(mIU/ml)
准爸爸精子活力(A+B%)
宝宝性别要求
试管助手成功率的算法基于真实用户的大数据信息,为防止虚假数据干扰准确性,请输入手机号以确保用户信息的真实性:
您的试管成功率为1%
由于HIV病毒可以通过性接触、血液以及母婴途径传播,因此生育一个健康的宝宝对于HIV感染者来说似乎是一个遥不可及的梦想,随着医学的进步和泰国试管婴儿洗精技术的成熟,HIV感染者艾滋病做试管婴儿已经不再是天方夜谭。今天,试管姐姐就为HIV感染者朋友详细说说具体流程。

HIV感染者为男性
如果HIV感染者是男性,那么在泰国试管婴儿过程中就需要运用到精子洗涤技术和泰国第三代试管婴儿的PGD/PGS基因筛查技术。

精子洗涤技术的正式名字是离心精浆分离技术,HIV感染者的病毒存在于精浆中,但精子是健康的。所以精子洗涤术就是将精液注入试管内,然后混入渗透剂,混合物经过离心机高速旋转后,将含有HIV病毒的精浆浮在液面。这种方法可以除去病毒,提取到健康的精子,再用试管婴儿体外受精技术将健康精子与卵子结合形成受精卵,之后再通过PGD/PGS筛查技术对胚胎进行检测,在双重筛选下,以确保移植入母体的胚胎是健康的,能从根源上将HIV病毒剔除出去,这样就可以生育健康宝宝了。
HIV感染者为女性
如果HIV感染者是女性,那么就需要使用供卵试管+第三方辅助生殖技术。因为母婴传播是最直接的感染方式,感染了HIV的女性,在怀孕、分娩或产后哺乳等过程都会将HIV病毒传染给胎儿,导致宝宝感染。HIV母婴传播的发生率高达50%至60%,因此,想要安全获得未感染HIV的健康宝宝,唯一的方式就是供卵试管+第三方辅助生殖技术,如直接想通过泰国试管婴儿技术来获取健康宝宝是不可以的。
现在这个时代,艾滋病做试管婴儿一点也不稀奇,泰国试管婴儿已经成为HIV感染者生育健康宝宝的理想选择。想要了解更多关于HIV感染者做试管婴儿的信息,可以微信咨询试管姐姐的医疗顾问,扫码立刻索取费用明细:

Copyright © 2019 试管姐姐 All Rights Reserved | 网站地图 | 粤ICP备20025016号-1技术支持:鹅鹅鹅科技
已有1383人测试
准妈妈年龄(岁)
备孕难题
试管次数
男方情况
子宫情况
准妈妈AMH(ng/ml)
准妈妈卵泡个数
准妈妈FSH(mIU/ml)
准爸爸精子活力(A+B%)
宝宝性别要求
试管助手成功率的算法基于真实用户的大数据信息,为防止虚假数据干扰准确性,请输入手机号以确保用户信息的真实性: